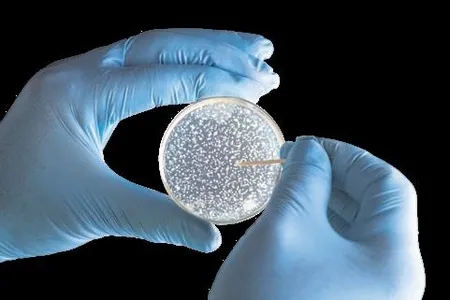

İnsanlık, asırlardır bakteri ve virüslerle iç içe yaşıyor. Biz onlara karşı direnç geliştirirken onlar da bizi hasta etmenin yeni yollarını buluyor. Bir asırdır yeni bir silahla onlara saldırdık: Antibiyotik. Onlar da yavaş yavaş antibiyotiklere karşı direnç geliştirdi. Bakteri ve virüslerle savaşımız devam ediyor. Ancak son yüzyılda bu savaşta daha önce karşımıza çıkmayan yepyeni bir soru ile karşı karşıyayız: Binlerce yıldır karşılaşmadığımız ya da hiç görmediğimiz zombi virüs ve bakterilerle karşı karşıya kalırsak ne olacak?
2016 yazı, Sibirya'nın ücra köşelerinde çok daha sıcak geçti. Ağustos 2016'da 2 bin Ren geyiği telef oldu. Önce sıcaklığın buna neden olduğu düşünüldü. Ancak 12 yaşında bir çocuk şarbon vakasından hayatını kaybedince, geyikleri öldürenin şarbon bakterisi olduğu anlaşıldı. En az 20 kişi şarbon hastalığına yakalandı. Şarbon, bölgede yıllardır yoktu; Yamal yarım adasının ücralığı göz önüne alındığında söz konusu hastalıkların terörist bir saldırı olduğu da iddia edilemezdi. İyi de hastalık nereden gelmişti?
Hastalığın gizemi kısa sürede çözüldü. 75 yıl önce hayatını şarbondan kaybeden bir Ren geyiği, donmuş toprak altında kaldı. Burada donuk halde duran geyik, 2016 yazı sıcaklarının etkisi ile serbest kaldı ve çevreye su aracılığı ile şarbon bakterisini yaydı. Yani 75 yıldır buzun altında saklanan şarbon bakterisi serbest kalarak bu salgına neden oldu.
BUZULLARDAKİ ERİYEN BAKTERİLER
Hastalığın önüne geçilmesi, sizi rahatlatabilir. Ama bu olay, bize daha tehlikeli olayların uyarısı niteliğinde olabilir. Küresel ısınma sonucunda yükselen sıcaklıklar -ki bu yükseliş kutup bölgesinde üç kat daha hızlı gerçekleşiyor- her yıl 50 cm'lik buzun erimesine neden oluyor. Bunun sonucunda buz altında kalan katmanlar açığa çıkıyor. Donmuş toprak, virüs ve bakterileri milyonlarca yıl hayatta tutabilecek ideal bir ortam. Bu da 75 yıl önce açığa çıkan Ren geyiği ve şarbon hastalığı gibi binlerce hatta belki milyonlarca yıldır saklı kalmış virüs ve bakterilerin açığa çıkmasına neden olabilir.
Buzulların altından virüs ve bakterilerin canlı bir şekilde çıkabileceği iddiası, içi boş bir komplo teorisi değil. Mesela bilim insanları, Alaska'daki Brevik Mission Köyü'nde 1918 yılında kazılmış toplu bir mezardan aldıkları bir akciğer dokusundan, bu kişilerin ölümüne yol açan İspanyol gribini oluşturmayı başardılar. İspanyol gribi, 100 yıl önce dünya çapında 50 ile 100 milyon kişinin ölümüne yol açan, bu köyün nüfusunun yüzde 90'ının canına mal olan çok tehlikeli bir virüstü. Bu türünün tek örneği de değil.

8 MİLYON YIL ÖNCESİNDEN BAKTERİ
2005 yılında NASA'lı bilim insanları, 32 bin yıl önce buzul çağda Alaska'da donan Carnobacterium pleistocenium isimli bir bakteriyi yeniden hayata döndürmeyi başardılar. Mamutlar zamanında yaşayan bu bakteri, bir anda kendini çağımızda buldu. İki yıl sonra bilim insanları, Antarktika'dan çıkarılan buzlardan çeşitli bakterileri canlandırmayı başardılar. Bu bakterilerden bir kısmı 100 bin yıl önceye aitken, biri tam 8 milyon yıl öncesine aitti.
Elbette bu bakteriler modern insandan önceki bir tarihten geldikleri için antibiyotiklerimize karşı direnç geliştirmemişlerdir diye rahatlayabiliriz diye düşünenleriniz olabilir. Ancak ne yazık ki bu bakterilerin antibiyotiklerimize karşı dirençli olup olmadıklarını bilmemize imkân yok.
TROPİKAL SALGINLAR YAYILABİLİR
Mesela bilim insanları, ABD'deki New Mexico Eyaletine bağlı Carlsbad'deki bir mağaranın 400 metre derinliğinde bir bakteri keşfetti. Bakteri 4 milyon yıldır yüzey ile temas etmemişti. Söz konusu mağara o kadar izoleydi ki hiç güneş yüzü görmüyor, yağan yağmurun yüzeyden içeri girmesi 10 bin yıl sürüyordu. 4 milyon yıldır yüzeyle temas etmeyen, dolayısıyla insanlarla da teması olmayan bu bakterinin çok güçlü antibiyotikler dahil, 18 adet antibiyotiğe karşı dirençli olduğu keşfedildi. Bu bakteri zararlı olmasa da yeraltından çıkacak başka bakterilerin benzer şekilde antibiyotiklere dayanıklı olup, insanlar için ölümcül olması pekala mümkün.
Elbette panik yapmamıza gerek yok. Henüz böyle bir virüs ortaya çıkmadı. Ama bu senaryonun bize gösterdiği bir nokta, küresel ısınmanın öngörülemeyen çok sayıda felakete yol açabileceği. Üstelik küresel ısınmanın tek tehdidi bu zombi bakteriler değil. Ilıman iklimin hakim olduğu bölgelerde tropikal sıcakların belirmesi, bu bölgelerde çeşitli zararlı hastalıklar taşıyan sivrisinek ve kenelerin ortaya çıkmasına ve tropikal salgınların yayılmasına neden olabilir. Bu küresel felaketlerden kurtulmanın en ucuz ve kestirme yolu ise küresel ısınma ile mücadele etmek.
BİLİM TARİHİNDEN NOTLAR
 Bak şu Ampere'in dalgınlığına
Bak şu Ampere'in dalgınlığına
Andre-Marie Ampere (1775-1836) ünlü Fransız fizikçi ve matematikçidir. Elektromanyetik kuramın kurucularındandır, bu alanda yaptığı çalışmalardan dolayı elektrik akım şiddeti birimine ismi verilmiştir. Ampere dalgınlığı ile ünlüydü. Devamlı düşüncelere dalar fizik ya da matematiksel problemlerle meşgul olurdu. Bir gün yolda yürürken aklına bir matematik probleminin çözümü geldi, unutmamak için hemen cebinden bir tebeşir çıkarıp tahta görevi görecek bir şey aramaya başladı. Önünde bulduğu düz alan üstüne denklemleri yazıp hesap yapmaya başladı. Ancak kısa bir süre sonra denklemleri yazdığı 'tahtanın' uzaklaşmaya başladığını gördü. Hızla 'tahtanın' arkasından koştu ama yetişemedi. Tahta olarak kullandığı şey bir at arabasının arkasıydı. Çaresizce yazdığı çözümlerin kaçıp gidişini seyretti.
ŞAŞIRTAN GERÇEKLER
 Oda soğudukça kâbus görme ihtimaliniz artar.
Oda soğudukça kâbus görme ihtimaliniz artar.
 Bazı insanlar 80 desibel seviyesinde horlayabilir. Yani bu kişiler horlarken beton matkabı kadar çok ses çıkarırlar.
Bazı insanlar 80 desibel seviyesinde horlayabilir. Yani bu kişiler horlarken beton matkabı kadar çok ses çıkarırlar.
 Ringa balıkları yellenerek iletişim kurarlar.
Ringa balıkları yellenerek iletişim kurarlar.
 Ortalama bir otomobilde 30 bin parça vardır.
Ortalama bir otomobilde 30 bin parça vardır.
SÖZLER
Bir okul fazla yapın, bir hapishane eksiltmiş olursunuz.
Victor Hugo
DOĞRU BİLDİĞİMİZ YANLIŞLAR
 Roma yanarken Neron'un keman çaldığı söylenmektedir. Bu iddia doğru olamaz zira keman 15. yüzyılda, Roma İmparatorluğu'ndan çok sonra keşfedilmişti.
Roma yanarken Neron'un keman çaldığı söylenmektedir. Bu iddia doğru olamaz zira keman 15. yüzyılda, Roma İmparatorluğu'ndan çok sonra keşfedilmişti.

 Güneş Sistemi'nde en çok sıvı su bulunan gök cisminin Dünya olduğu zannedilir. Oysa bu doğru değildir; Jüpiter'in uydusu Europa'da Dünya'nın iki katı daha fazla su bulunuyor.
Güneş Sistemi'nde en çok sıvı su bulunan gök cisminin Dünya olduğu zannedilir. Oysa bu doğru değildir; Jüpiter'in uydusu Europa'da Dünya'nın iki katı daha fazla su bulunuyor.
BİLİMSEL BİLMECELER
 Bir tedarikçi ağırlıkla metal satın alıp bunu satarak kar etmek istemektedir. Karını arttırmak için metali yüksek rakımda satın alıp düşük rakımda mı satmalıdır? Yoksa tersini mi yapmalıdır?
Bir tedarikçi ağırlıkla metal satın alıp bunu satarak kar etmek istemektedir. Karını arttırmak için metali yüksek rakımda satın alıp düşük rakımda mı satmalıdır? Yoksa tersini mi yapmalıdır?
 Kirli kar mı yoksa temiz kar mı gün ışığında daha çabuk erir?
Kirli kar mı yoksa temiz kar mı gün ışığında daha çabuk erir?
Çözümü haftaya Pazar SABAH'ta
GEÇEN HAFTANIN ÇÖZÜMLERİ
 Cevap 12'dir. Saat 6 vuruşta 5 duraksama vardır. Dolayısıyla 5 duraksama 6 saniye sürmektedir. 11 vurduğunda 10 duraksama olacaktır. Dolayısıyla ortalama 12 saniyelik bir zaman geçecektir.
Cevap 12'dir. Saat 6 vuruşta 5 duraksama vardır. Dolayısıyla 5 duraksama 6 saniye sürmektedir. 11 vurduğunda 10 duraksama olacaktır. Dolayısıyla ortalama 12 saniyelik bir zaman geçecektir.
 Cevap üçtür. Bir sırada üç çocuk yürürse bahsedilen bütün şartlar sağlanır.
Cevap üçtür. Bir sırada üç çocuk yürürse bahsedilen bütün şartlar sağlanır.